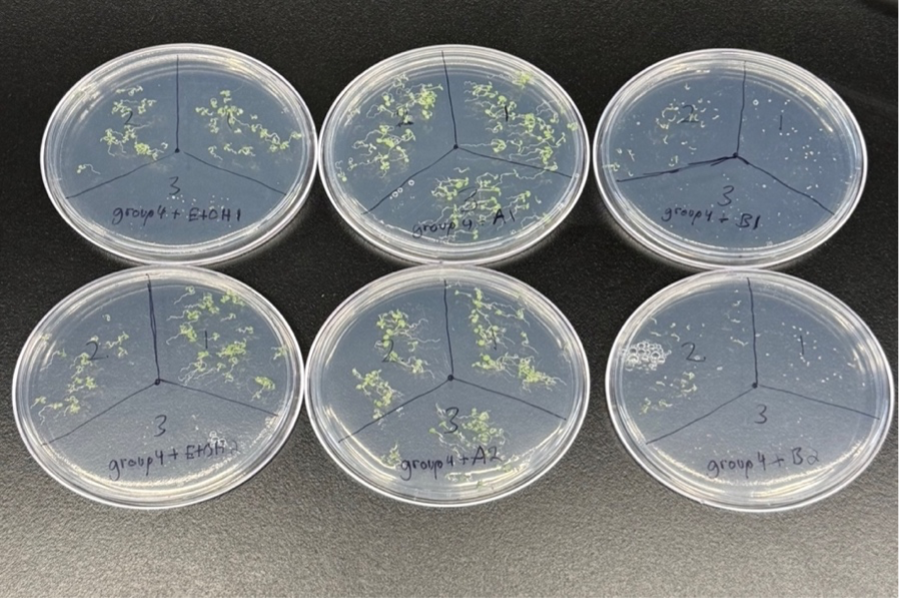
Article thumbnail

Pain, as one of the major clinical and social problems, still lacks effective objective evaluation indicators. At present, nearly one in five adults suffer from different types and different parts of pain. An important feature of clinical pain is persistent pain, in addition to sensory discrimination processes, it involves a range of brain regions involved in top-down cognitive and emotional processing. However, clinical pain is often affected by multiple factors and is difficult to assess objectively. Recently, blood, urine, cerebrospinal fluid, and biopsy tissue have been identified using novel, sensitive, and specific protein analysis methods in an attempt to detect changes in biological markers associated with different pain types. This paper will summarize the biological markers related to different parts of pain in the latest relevant studies at home and abroad and focus on the application prospect of such biological markers in the diagnosis, treatment, and prognosis evaluation of the pain.
Research Article
Open Access